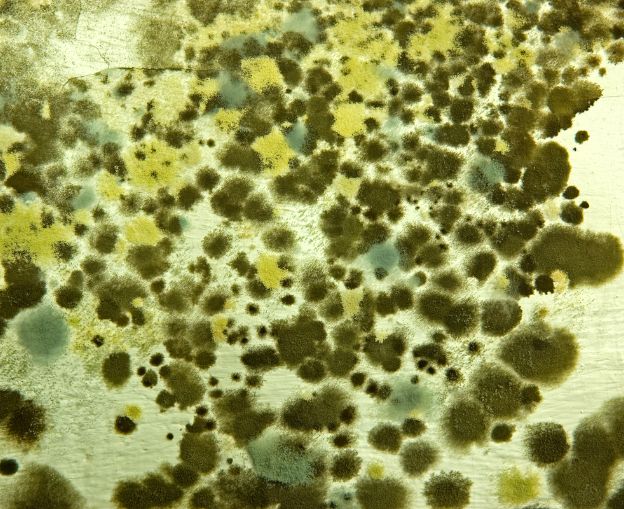
Close-up of mold growth on a surface, showing various fungal colonies.

Health Systems Sciences (HSS) — Protecting Occupants, Facilities, and Building Health
HSS provides comprehensive mold investigation, assessment, sampling, and remediation oversight services for healthcare facilities, hospitals, laboratories, government buildings, and commercial properties.
We identify the source, evaluate the extent, and help develop clear corrective actions that restore safe indoor conditions.
As a Service-Disabled Veteran–Owned Small Business (SDVOSB), we support VA Medical Centers, DoD campuses, academic institutions, and private health systems nationwide.
Core Mold Investigation Services
Core Mold Investigation Services
Clear, Defensible Reporting
Clear, Defensible Reporting
- Identification of mold type and concentration levels
- Source tracing and contributing condition findings
- Action levels referenced to industry guidelines (ASHRAE, ACGIH, AIHA)
- Practical remediation guidance (no upsell, no scare tactics)
- Restoration and verification sampling (post-remediation clearance)


